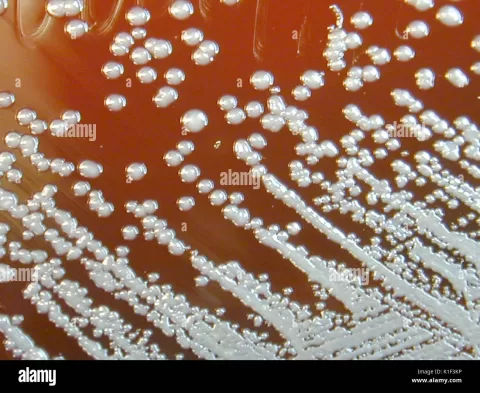

Henipavirus, a member of the Paramyxoviridae family, has recently piqued interest due to the discovery of Camp Hill virus in the northern short-tailed shrew population in Alabama, USA. This finding has raised important questions about zoonotic transmission and the potential pandemic risks associated with henipa-like viruses. As the research unfolds, the genetic distinction of Camp Hill virus, categorized under Parahenipavirus, adds a layer of complexity to our understanding of these emerging pathogens. Despite growing concerns, there have been no documented human infections related to this virus, offering a temporary sigh of relief in a time of heightened vigilance. Nevertheless, the lack of comprehensive studies on its reservoir species and potential spillover in different mammals underscores the need for ongoing research into the implications of henipavirus in public health.
The recent characterization of a new henipavirus variant brings to light the importance of monitoring closely related viral agents, particularly those classified under the genus Parahenipavirus. This category encompasses viruses that could potentially infect various wildlife species, including small mammals like the northern short-tailed shrew. With significant media attention on zoonotic outbreaks and their effects on human health, it is crucial to evaluate the evolutionary links between emerging pathogens such as Camp Hill virus and other known viruses, including well-studied ones like the Hendra and Nipah viruses. Understanding the dynamics of such viruses not only aids in preparedness against possible zoonotic infections but also illuminates the ecological aspects of viral transmission. As we delve deeper into the implications of these studies, it becomes evident that the pandemic risks posed by henipaviruses warrant close scrutiny and proactive surveillance.
Understanding Henipaviruses: The Risks and Research
Henipaviruses, including the recently identified Camp Hill virus, belong to a broader family of viruses that have shown the potential for zoonotic transmission. This means they can be transmitted from animals to humans, raising critical concerns among health experts about their pandemic risks. Notably, the northern short-tailed shrew has emerged as a noteworthy host for these viruses, further complicating our understanding of their ecological impact. The presence of these viruses in shrews taps into the complex dynamics of wildlife, such as the northern short-tailed shrew, and their environments that facilitate the spillover of viruses into human populations.
Current research suggests that the evolutionary journey of henipaviruses, specifically the parahenipavirus genus, is not only diversified but also includes a variety of host species. Comprehensive studies are required to explore these viruses’ transmission pathways and potential zoonotic risks fully. With the emergence of novel viruses, including Camp Hill, investigating their prevalence in wildlife, alongside potential human exposure, is crucial for understanding and mitigating future pandemic threats.
The Role of Zoonotic Transmission in Viral Emergence
Zoonotic transmission is a critical factor in the emergence of henipaviruses, including the Camp Hill virus discovered in Alabama. The interaction between wildlife species, such as the northern short-tailed shrew, and human populations creates unique opportunities for viruses to jump species. Though no human infections linked to the Camp Hill virus have been documented, the historical context of similar viruses demonstrates the importance of vigilance in monitoring wildlife reservoirs. For instance, the Langya virus, linked with febrile patients in China, exemplifies the potential for zoonotic spillover that can lead to public health crises.
As scientists explore the viral landscape of the Camp Hill virus and its relatives within the parahenipavirus genus, the implications of zoonotic transmission become increasingly pertinent. Understanding the mechanisms behind these transmissions can significantly inform epidemiological studies and public health strategies. This understanding not only focuses on influencing risk management protocols but also emphasizes the necessity for comprehensive surveillance of wildlife species that harbor emerging viruses, thereby safeguarding against unforeseeable epidemiological events.
Camp Hill Virus: A Case Study in Emerging Wildlife Viruses
The Camp Hill virus serves as an intriguing case study within the context of emerging wildlife viruses. First discovered in the northern short-tailed shrew, this virus highlights the potential risks presented by lesser-known hosts in zoonotic diseases. While the current representation of Camp Hill virus raises no immediate alarm due to the absence of human infections, its identification signifies a critical step in recognizing the myriad of viruses present in wildlife that could harbor unknown threats. As with other similar viruses, understanding Camp Hill’s genetics and its potential reservoirs is vital for developing effective pandemic response strategies.
Moreover, the establishment of Camp Hill virus within the parahenipavirus genus underscores the importance of continued research in this area. Scientists emphasize the need for thorough viral characterization and genetic analysis to determine the full spectrum of risks that these viruses present. By thoroughly understanding Camp Hill and its relatives’ ecology and epidemiology, researchers can better assess their implications for wildlife health, human health, and overall ecosystem stability.
Potential Pandemic Risks Associated with Henipaviruses
The potential pandemic risks associated with henipaviruses, such as Camp Hill virus, are becoming increasingly apparent as new species are discovered that host these pathogens. The relationship between wildlife and human populations is at a pivotal tipping point, where the health of one directly influences the other. The emergence of henipaviruses in shrews prompts discussions around ecological balance, wildlife conservation, and public health initiatives. Strategies that promote habitat preservation may reduce the likelihood of zoonotic spillover events and lower the overall risk of future pandemics.
Despite the present lack of documented human cases of Camp Hill virus, preparedness remains paramount. The global health community has recognized the importance of establishing frameworks to identify and respond to emerging infectious diseases. It is essential to invest in research focusing on the epidemiology of viruses, including non-pathogenic strains, to prevent potential outbreaks. Enhancing our comprehension of how these viruses interact within ecosystems and impact human health is crucial for averting public health crises in the future.
Research Gaps in Henipavirus Studies
The discovery of the Camp Hill virus highlights significant research gaps in the understanding of henipaviruses and their transmission dynamics. Despite notable findings, limited serological studies and a lack of viral isolates create uncertainty regarding the risks posed by these pathogens. For instance, while initial research indicates a divergence from highly pathogenic species like Hendra and Nipah, the potential for unrecognized pathogenicity exists within the parahenipavirus group. Addressing these knowledge gaps through systemic investigations will be vital in assessing the risks of zoonotic transmission effectively.
Future studies must prioritize the investigation of parahenipaviruses in diverse wildlife species, especially those that have not been extensively studied. The northern short-tailed shrew, being a newly recognized host, represents just one of many species that may harbor related viruses. Comprehensive ecological and epidemiological research can unravel the complexities surrounding these viruses and their interactions with various hosts, ultimately contributing to a more informed risk assessment framework.
Ecological and Evolutionary Perspectives on Henipaviruses
The ecological and evolutionary dynamics surrounding henipaviruses are critical to understanding their emergence and potential impacts on human health. The unique habitat of the northern short-tailed shrew may create favorable conditions for viral evolution and transmission. As these shrews coexist with numerous environmental variables, studying these interactions can help uncover how henipaviruses conduct their life cycle and maintain their presence within wildlife. The emergence of the Camp Hill virus prompts an important dialogue on how habitat changes influence viral evolution.
Additionally, the evolutionary trajectory of viruses such as Camp Hill highlights the importance of genetic diversity in viral populations. This diversity within parahenipaviruses may enhance the adaptability of these pathogens to new hosts, including humans. Understanding the evolutionary mechanisms that govern viral emergence and transmission is crucial for predicting and mitigating future outbreaks. By incorporating an ecological perspective into viral studies, researchers can develop comprehensive strategies to monitor potential threats, ensuring a proactive approach in public health.
Interdisciplinary Approaches to Virus Research
Addressing the complexities of henipavirus research, particularly in the context of emerging threats like the Camp Hill virus, necessitates interdisciplinary approaches. Collaborations between virologists, ecologists, epidemiologists, and public health experts can foster a comprehensive understanding of zoonotic diseases. Bringing together diverse perspectives will enhance our ability to assess risks associated with viruses and develop multidisciplinary strategies for monitoring and response. This approach is essential to navigate the evolving landscape of infectious diseases like henipaviruses.
Furthermore, interdisciplinary research can inform public health policies and conservation efforts alike. Recognizing the interconnectedness of wildlife health, environmental stability, and human health can guide strategies that aim to reduce zoonotic transmission risks. Integrating ecological insights with virology and epidemiology paves the way for innovative surveillance initiatives, ultimately supporting the global effort to anticipate and mitigate emerging pandemic threats.
Implications for Wildlife Conservation and Public Health
The implications of henipaviruses, particularly through the lens of the Camp Hill virus, illustrate the critical interdependencies between wildlife conservation and public health. Protecting habitats inhabited by high-risk species, such as the northern short-tailed shrew, not only supports biodiversity but also reduces the chances of zoonotic spillover events. Conservation efforts aimed at preserving ecosystems can significantly lower public health risks by minimizing interactions between wildlife and human populations where viral transmission could occur.
In addition to habitat protection, public health policies must adapt to the changing dynamics of zoonotic diseases. With the emergence of viruses like Camp Hill, it is evident that monitoring wildlife is essential for early detection of potential threats. By fostering a close relationship between conservation biology and public health initiatives, proactive measures can be enacted. This strategic alliance can help develop comprehensive plans that prioritize both the health of wildlife and the protection of human health, thereby mitigating future pandemic risks.
Future Directions in Henipavirus Research
Looking ahead, future directions in henipavirus research should emphasize the need for comprehensive studies that elucidate the biological and ecological aspects of these viruses. The discovery of the Camp Hill virus exemplifies the importance of proactive surveillance and investigation of wildlife reservoirs. Focusing on expanding research efforts to understand the full spectrum of parahenipaviruses, particularly in understudied species, could significantly inform risk assessments and pandemic preparedness strategies.
Additionally, interdisciplinary approaches will play a crucial role in addressing existing knowledge gaps and enhancing our understanding of henipaviruses. Embracing technology, such as advanced genomic sequencing and ecological modeling, can lead to breakthroughs in detecting and analyzing viral behaviors. Such advances will ultimately contribute to developing effective infectious disease management strategies, thereby safeguarding human populations from the ever-evolving landscape of zoonotic threats.
Frequently Asked Questions
What is Henipavirus and how does it relate to zoonotic transmission?
Henipavirus is a genus of viruses within the family Paramyxoviridae, known for their potential to cause severe disease in both animals and humans. Notably, certain species like the Camp Hill virus, recently discovered in the northern short-tailed shrew, have raised concerns about zoonotic transmission, indicating the capability of the virus to jump from animals to humans. Understanding the transmission dynamics of Henipavirus is crucial for assessing public health risks.
Has Camp Hill virus been linked to any human infections?
Currently, there have been no documented human infections associated with Camp Hill virus, despite its identification in the northern short-tailed shrew. This absence of cases suggests a limited immediate risk to human health; however, ongoing surveillance and research about Henipavirus and related parahenipaviruses remain essential to monitor potential zoonotic transmission.
What are the pandemic risks of parahenipaviruses like Camp Hill virus?
Though parahenipaviruses, including Camp Hill virus, are genetically distinct and appear predominantly in shrew species, the potential for pandemic risks cannot be entirely dismissed. The discovery of similar viruses highlights the need for further research to understand their zoonotic capabilities and to evaluate any spillover risks to humans, especially in light of the historical emergence of related viruses.
What is the significance of the northern short-tailed shrew in studying Henipavirus?
The northern short-tailed shrew (Blarina brevicauda) has recently been identified as a host for Camp Hill virus within the spectrum of Henipavirus research. Its role as a potential reservoir species offers insights into the ecology and evolution of parahenipaviruses, but it also emphasizes the importance of studying such species for understanding zoonotic disease risks.
How does the emergence of parahenipavirus relate to Camp Hill virus and zoonotic diseases?
The classification of certain henipa-like viruses as parahenipaviruses, such as Camp Hill virus, underscores a growing recognition of diverse virus groups that may share zoonotic potential. While no human infections have been reported for Camp Hill virus, the presence of related viruses in shrews prompts caution regarding their evolutionary path and the need for further studies to mitigate zoonotic risks.
What are the findings from recent studies on Henipavirus in small mammals?
Recent studies have identified novel orthoparamyxoviruses, including the Camp Hill virus and others in European white-toothed shrews. These findings highlight the diversity of henipaviruses in small mammals and emphasize the necessity for comprehensive research to assess their zoonotic transmission risks to humans and the potential implications for public health.
Why is research on Camp Hill virus and Henipavirus important for public health?
Research on Camp Hill virus and other members of the Henipavirus genus is critical for public health because it aids in understanding the risk of zoonotic diseases spreading from wildlife to humans. Given the prior occurrences of henipavirus outbreaks, proactive studies can inform risk management and prepare health systems for potential zoonotic transmission events.
| Key Point | Details |
|---|---|
| Discovery | Camp Hill virus found in northern short-tailed shrew in Alabama. |
| Zoonotic Transmission | No human infections with Camp Hill virus documented so far. |
| Taxonomy | Related henipa-like viruses categorized as a distinct genus, Parahenipavirus. |
| Global Occurrence | Parahenipaviruses are widespread among shrew species but limited in non-shrew species. |
| Significance | Lack of evidence for human infection suggests limited zoonotic potential. |
| Need for Research | Future studies required for understanding spillover risks and risk management. |
Summary
Henipavirus, particularly Camp Hill virus, recently discovered in shrews, presents essential findings that could reshape our understanding of potential zoonotic diseases. Despite the media interest surrounding its implications, no human infections have been recorded, making it crucial to approach related viruses with caution. Identifying the genetic distinctions between Camp Hill and more dangerous henipaviruses may inform future risk assessments and healthcare strategies. The ongoing research will help clarify spillover risks, emphasizing the need for thorough studies in regions where these viruses are prevalent.
The content provided on this blog (e.g., symptom descriptions, health tips, or general advice) is for informational purposes only and is not a substitute for professional medical advice, diagnosis, or treatment. Always seek the guidance of your physician or other qualified healthcare provider with any questions you may have regarding a medical condition. Never disregard professional medical advice or delay seeking it because of something you have read on this website. If you believe you may have a medical emergency, call your doctor or emergency services immediately. Reliance on any information provided by this blog is solely at your own risk.